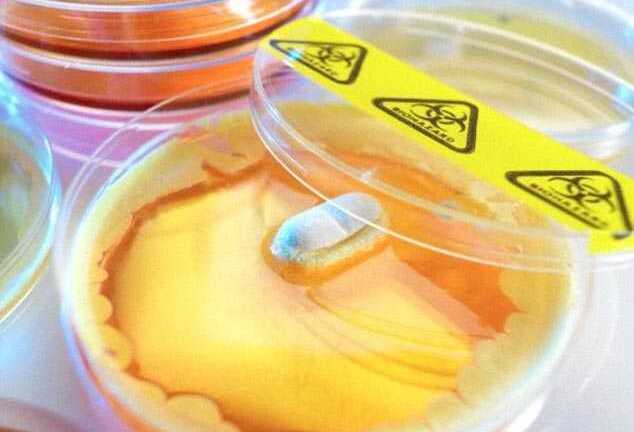
Phát hiện siêu kháng sinh có thể chữa hầu hết các bệnh

Phát hiện siêu kháng sinh có thể chữa hầu hết các bệnh
Các nhà nghiên cứu Mỹ vừa phát hiện một loại siêu kháng sinh có khả năng loại bỏ hầu hết các mầm bệnh, từ tụ cầu khuẩn vàng tới vi khuẩn lao,...
Các nhà nghiên cứu Mỹ vừa phát hiện một loại siêu kháng sinh có khả năng loại bỏ hầu hết các mầm bệnh, từ tụ cầu khuẩn vàng tới vi khuẩn lao,...